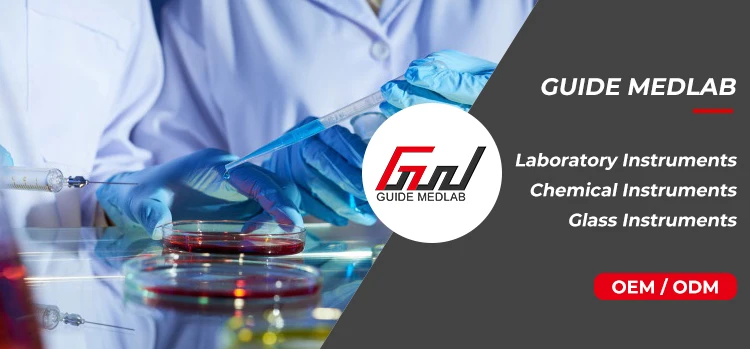

Share on (1600987343273):

Code | Name | Specification | Packing | Steril | PCS/CTN |
K08 | Transfer Pipette | 1ml | in bulk | No | 5000PCS/CTN |
K08 | Transfer Pipette | 1ml | individual | EO Steril | 3000PCS/CTN |
K09 | Transfer Pipette | 2ml | in bulk | No | 5000PCS/CTN |
K09 | Transfer Pipette | 2ml | individual | EO Steril | 3000PCS/CTN |
K10 | Transfer Pipette | 3ml | in bulk | No | 5000PCS/CTN |
K10 | Transfer Pipette | 3ml | individual | EO Steril | 3000PCS/CTN |
K11 | Transfer Pipette | 5ml | in bulk | No | 5000PCS/CTN |
K11 | Transfer Pipette | 5ml | individual | EO Steril | 3000PCS/CTN |







New products from manufacturers at wholesale prices